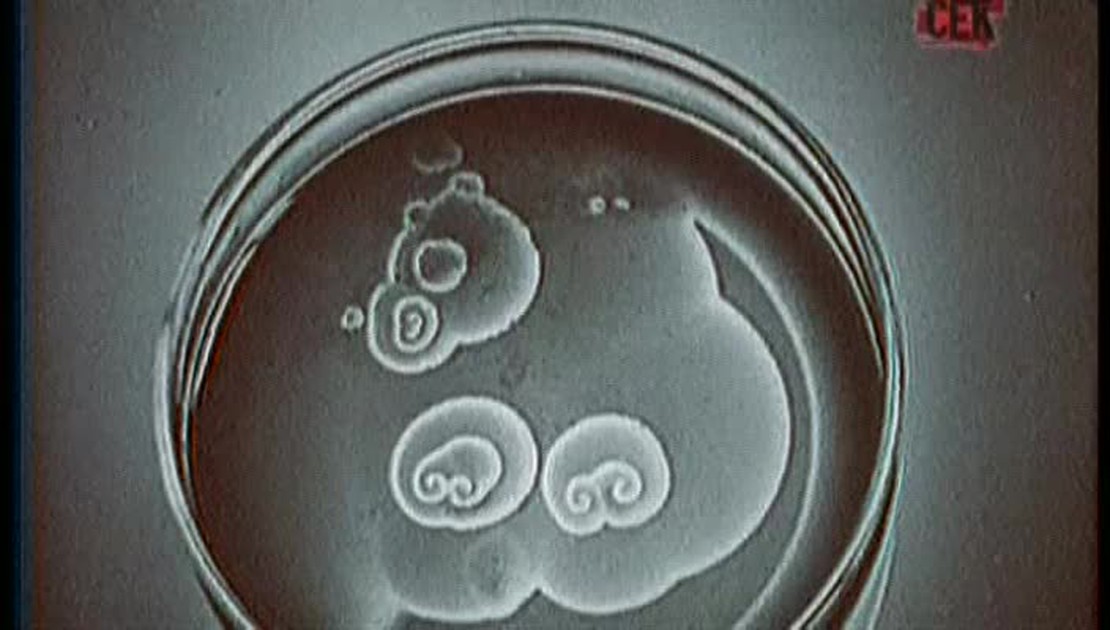

Документальное расследование. Наука
5
0
Еще во времена Советского Союза согласно статистике каждый четвертый ученый мира был нашим соотечественником. За последние 17-ть лет, картина резко изменилась. Количество людей некогда гордо носивших звание "советский ученый" сократилось на 2,5 миллиона. Сейчас их осталось чуть более миллиона. Бытует расхожее мнение, что основная масса наших талантливых мозгов высасывается алчным Западом. На самом деле лишь 1/10 ученых действительно уезжает в Соединенные Штаты Америки, или обретают новое место ж...
